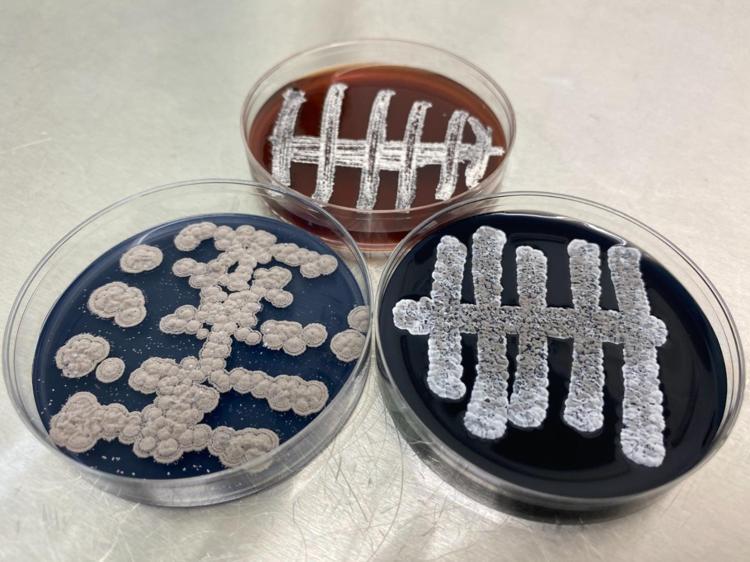
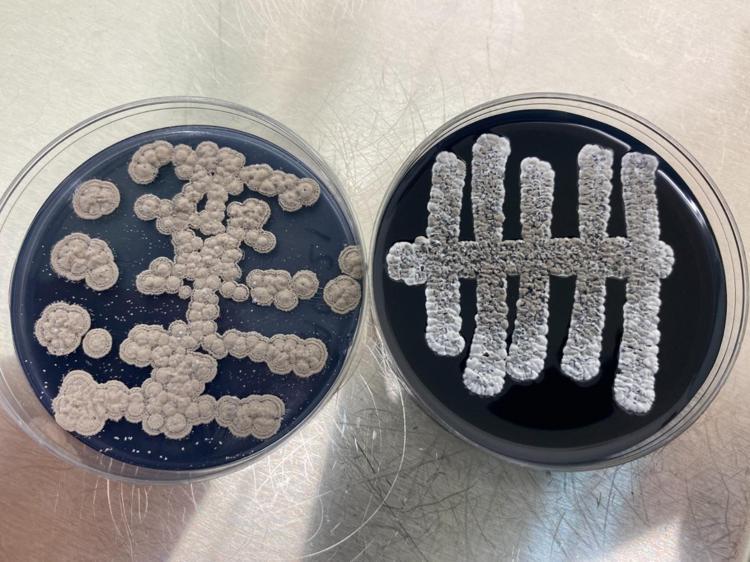
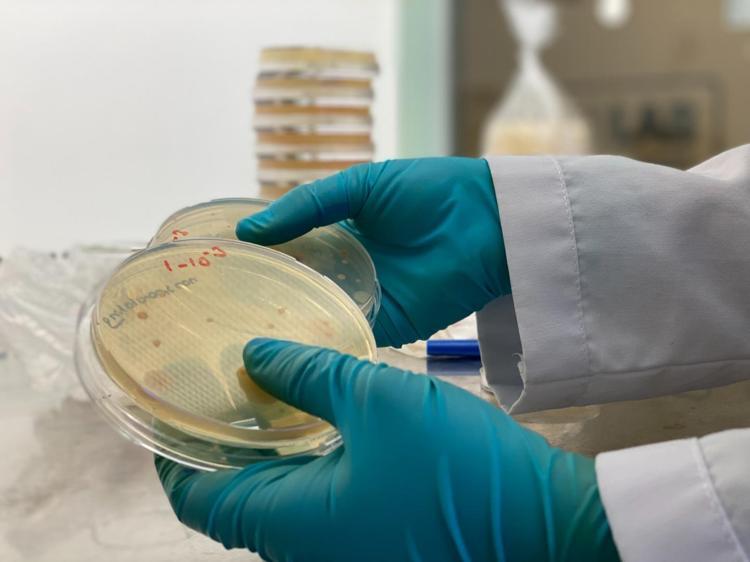

Türk bilim adamları, 6 ülkede 60 yeni tür bakteri keşfetti
Samsun Ondokuz Mayıs Üniversitesi (OMÜ) Fen-Edebiyat Fakültesi Moleküler Biyoloji ve Genetik Bölümü Başkanı Prof. Dr. Nevzat Şahin ve ekibi, 60 yeni tür bakteri keşfetti. Türkiye ile birlikte 6 ülkede 2 yıllık çalışma sonucu bulunan yeni türlerin isimlendirilip tanımlandıktan sonra literatüre girmesi bekleniyor. Şahin, "Bu bakteri türlerinin çoğunluğu genetik özellikleri bakımından antibiyotiğin kaynağı olma özelliğine sahiptir. Bunlarla ilgili yeni ilaç ve antibiyotik keşiflerine yönelik çalışmalarımız da var" dedi.
Zeynep Irmak ÖCAL- Tayfur KARA/SAMSUN, (DHA)-
• Son Güncelleme:
Zeynep Irmak ÖCAL- Tayfur KARA/SAMSUN, (DHA)-
• Son Güncelleme:
1

2

3

4

5
6
7
8

9

10

11

12

13

14

15

16





